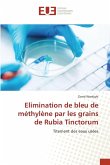
Elimination de bleu de méthylène par les grains de Rubia Tinctorum

De nombreux procédés chimiques ou encore physiques sont en application. Cependant, chacune de ces méthodes présente des avantages et des inconvénients. La recherche de méthodes alternatives ou complémentaires pour le traitement des eaux usées a conduit depuis quelques années à l'émergence de nouvelles technologies. Parmi ces technologies, les procédés dits d'oxydation avancés (POA) sont en plein essor. La photo Fenton, qui fait partie de ces POA, est un procédé d'oxydation catalytique mettant en jeu un photocatalyseur homogène avec le polluant et des rayonnements lumineux. Ce procédé repose sur la formation des radicaux hydroxyles HO , capables de minéraliser partiellement ou en totalité la plupart des composés organiques, il permet alors, la dégradation de molécules en phase aqueuse ou gazeuse et il a déjà prouvé son efficacité pour la minéralisation complète de nombreux polluants des eaux. Cette technologie, est appliquée au laboratoire donne des résultats satisfaisants, elle pourrait être extrapolée à grande échelle, et être une solution très intéressante, à moindre coût pour ce type d'eau de rejets, surtout pour un pays à fort ensoleillement comme l'Algérie.
Bitte wählen Sie Ihr Anliegen aus.
Rechnungen
Retourenschein anfordern
Bestellstatus
Storno